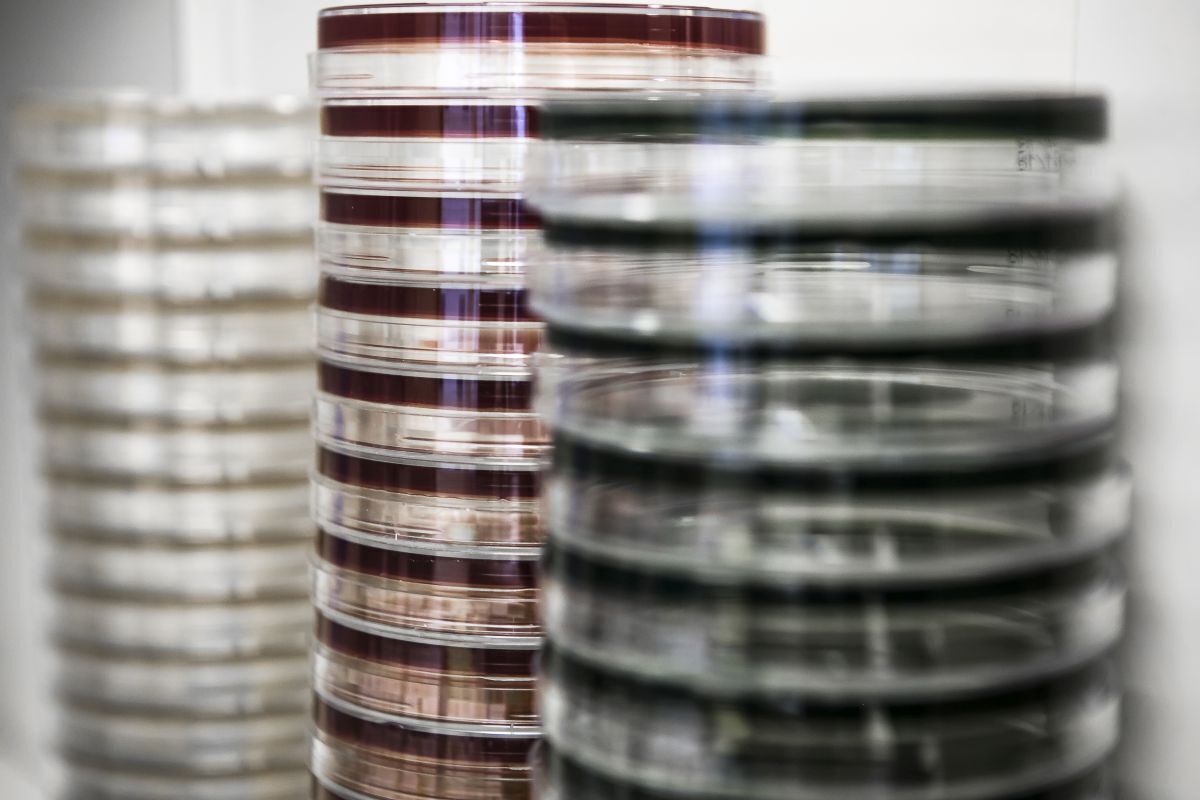
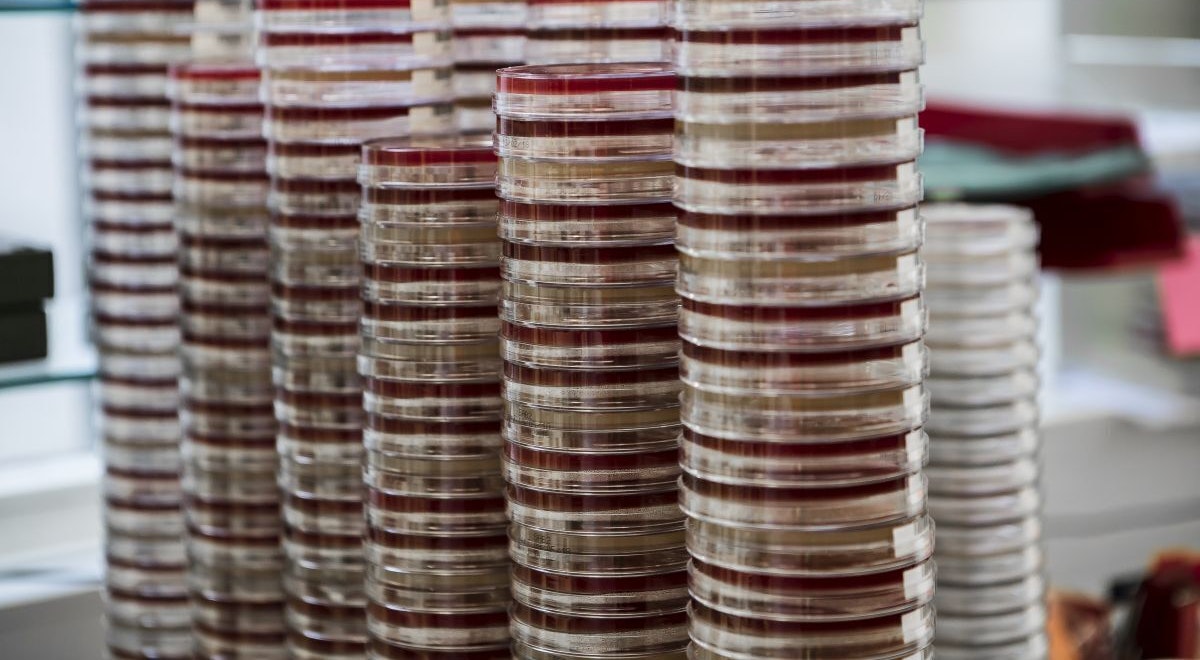
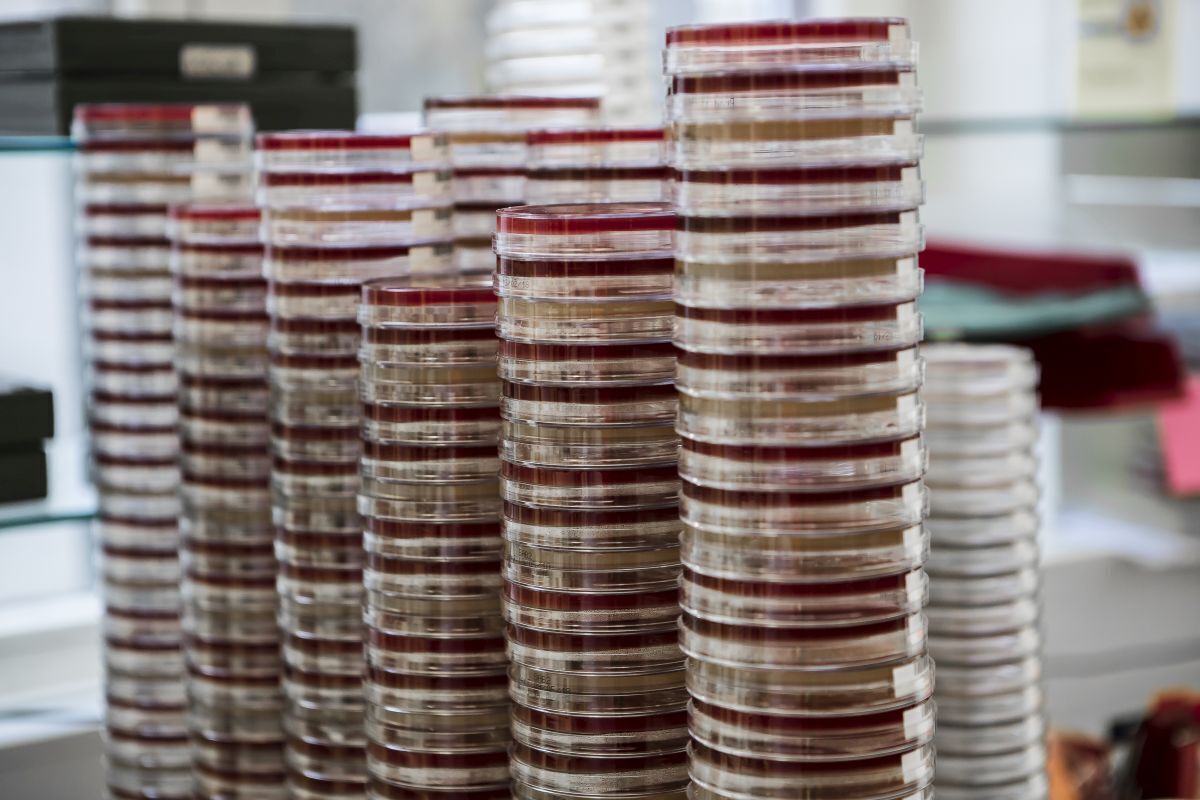

Medica
Starte deine Zukunft und bewerbe dich bei uns!
Videos und Fotos von Medica
Wir bieten dir als Medica die Chance auf einen erfolgreichen Start ins Berufsleben. Wenn du einen einmaligen Einstieg in die Berufswelt erleben möchtest, dann bist du bei uns genau richtig! Wir suchen motivierte und begeisterte Talente und bieten dafür ein dynamisches Arbeitsumfeld sowie spannende Projekte, bei denen du die Chance hast Neues zu lernen und deine Fähigkeiten weiterzuentwickeln.